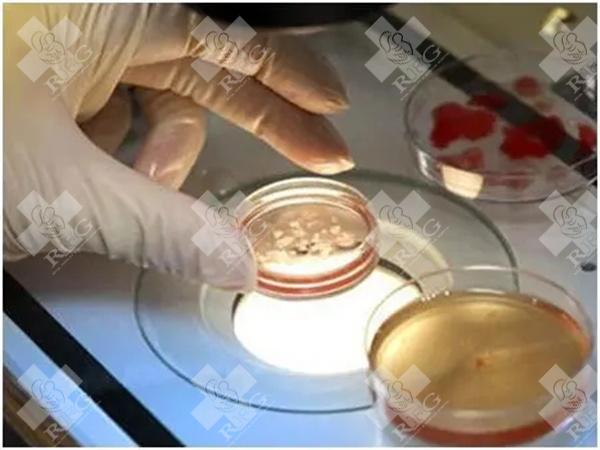
染色体是遗传信息的载体，它们承载着人类生长、发育和功能维持所需的基因。在生物学和医学领域，染色体检查已经成为一项重要的技术，它对于了解染色体的结构和功能、预防和治疗遗传性疾病等方面具有重要意义。那么，对于个体而言，是否有必要进行染色体检查呢？检查的意义又是什么呢？

发布时间:2024-01-26 10:56:22
柬埔寨皇家生殖遗传医院(RFG)
染色体是遗传信息的载体,它们承载着人类生长、发育和功能维持所需的基因。在生物学和医学领域,染色体检查已经成为一项重要的技术,它对于了解染色体的结构和功能、预防和治疗遗传性疾病等方面具有重要意义。那么,对于个体而言,是否有必要进行染色体检查呢?检查的意义又是什么呢?
首先,对于某些特定的人群,染色体检查是非常必要的。例如,高龄孕妇、既往生育过异常胎儿、不孕不育夫妇、有遗传性疾病家族史的人以及在辅助生殖过程中的人等,都应该进行染色体检查。这些人群中,染色体异常的风险较高,通过检查可以了解染色体的结构和数目是否正常,预测和预防遗传性疾病的发生,为后续的治疗和生育方案提供指导。
其次,染色体检查的意义不仅仅在于预测遗传性疾病的风险。通过检查,人们可以更好地了解自己的遗传信息,对于一些与染色体异常相关的疾病,如不孕不育、反复流产、智力发育迟缓等,可以及早发现并采取相应的治疗措施。此外,染色体检查还可以帮助人们了解自己的基因型和表型特征,对于一些与遗传相关的生理和心理特征,如身高、体重、智力、性格等,可以进行更好的自我认识和评估。
最后,染色体检查还有助于人们保护自己的隐私和尊重他人的隐私权。染色体检查结果属于个人隐私信息,应该得到妥善的保护和尊重。同时,人们也应该了解自己的权利和义务,保护自己的隐私信息并尊重他人的隐私权。
上一篇: 多囊卵巢手术成功率是多少?多囊卵巢手术可以成功吗?
上一篇: 单角子宫试管婴儿流程是什么
返回列表
推荐阅读
洛阳私立机构多囊肾可以做试管婴儿吗,附试管方案就成功率详解
洛阳作为河南省的重要城市,医疗资源相对丰富,不少私立医疗机构也具备辅助生殖技术的相关资质。对于多囊肾患者来说,能否做试管婴儿,关键在于病情的具体情况和身体条件是否适合进行辅助生殖治疗。开展人类辅助生殖...
2025-11-13 12:14:23
查看全部
南通私立机构试管不成功的原因有哪些,关键因素与改善建议
南通的私立医疗机构在辅助生殖技术,尤其是试管婴儿方面,确实为不少不孕不育家庭提供了帮助。不过,也有不少人经历过多次尝试仍未成功的案例。那么,为什么在南通的一些私立机构做试管婴儿会失败呢?我们可以从几个...
2025-11-13 10:34:07
查看全部
陈仓私立机构试管第二代成功率高吗,3个方法成功率翻倍
陈仓地区的一些私立机构提供试管婴儿服务,其中第二代试管婴儿技术(ICSI)已经比较成熟。这项技术主要适用于男性不育因素,比如精子数量少、活力差等情况。它通过将单个精子直接注射到卵子中来实现受精,提高了...
2025-11-13 08:56:10
查看全部
广东私立机构试管成功率高吗,这些成功率提升技巧你必须掌握
在广东,不少家庭因为各种原因选择通过试管婴儿技术来实现生育愿望。而除了公立医院,也有一些私立机构提供这类服务。很多人会问:广东的私立机构做试管婴儿成功率高吗?其实这个问题没有一个统一的答案,但我们可以...
2025-11-13 05:38:39
查看全部
临汾私立机构男性少弱精试管婴儿吗,诊疗方案与成功率全解析
临汾作为山西的一个地级市,近年来在医疗技术方面也有一定发展,特别是在辅助生殖技术方面,一些私立机构也逐渐涉足试管婴儿相关服务。不过,关于男性少弱精症的治疗和试管婴儿成功率,很多人还存在不少疑问。下面我...
2025-11-13 03:59:48
查看全部
天水私立机构二胎试管婴儿成功率高吗,二胎备孕成功率提升技巧
天水的一些私立医疗机构在辅助生殖技术方面确实有一定的发展,尤其是针对二胎家庭的需求,试管婴儿技术的应用也越来越多。那么,这些私立机构做试管婴儿的成功率到底怎么样呢?其实,成功率受很多因素影响,比如年龄...
2025-11-12 22:08:59
查看全部
青海私立机构amh0.21还能做试管吗,成功率大吗怎么提高
青海的这家私立机构,AMH值0.21还能不能做试管婴儿?成功率高不高?怎么提高成功率?这些问题其实挺常见的,很多人都会担心自己身体条件是否还适合做试管。下面我就用通俗易懂的方式,给你讲讲这些事。开展人...
2025-11-12 17:10:42
查看全部
河南私立机构试管婴儿第二次成功率是多少,二次移植成功率概览
在河南,一些私立医疗机构提供试管婴儿服务,很多人在第一次尝试失败后,会选择进行第二次试管婴儿移植。那么,第二次成功率大概有多少呢?其实,这个问题没有一个固定答案,因为成功率受很多因素影响。开展人类辅助...
2025-11-12 13:53:23
查看全部
宜昌私立机构试管婴儿囊胚移植成功率多高,成功率揭秘
说到试管婴儿,很多人心里都带着一份期待,也有一份忐忑。尤其是到了一定年纪,或者尝试自然怀孕失败多次之后,很多夫妻就会考虑通过辅助生殖技术来实现生育愿望。而在众多技术中,试管婴儿中的“囊胚移植”是近年来...
2025-11-12 12:13:48
查看全部
咨询热线
4000279913
微信客服
在线留言
返回顶部